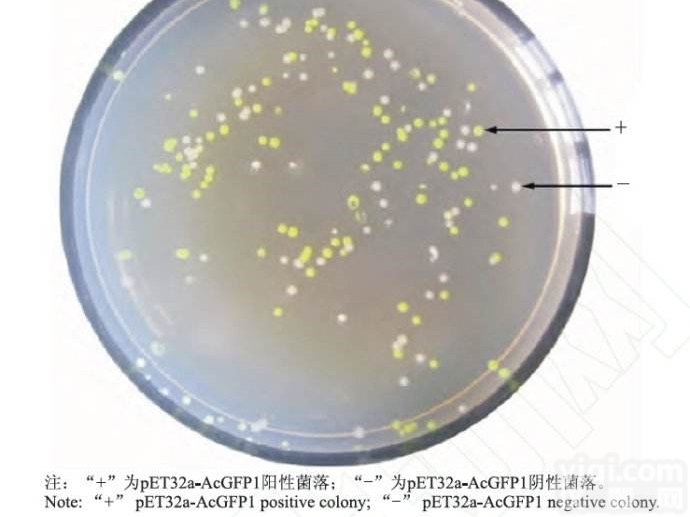
EHA105 电<em>转化</em><em>感受</em>态<em>细胞</em>

EHA105 电转化感受态细胞
- 品牌:cmbio
- 型号:EHA105
- 供应商:上海淳麦生物科技有限公司
- 供应商报价:面议
- 标签:电转化感受态细胞,-1,上海淳麦生物科技有限公司
| 品牌 | 其他品牌 | 供货周期 | 现货 |
|---|
EHA105农杆菌电转感受态细胞简要说明:
EHA105菌株由EHA101菌株改造而来,为C58型背景,核基因中含有筛选标签——利福平抗性基因rif,为了便于转化操作,此菌株携带一无自身转运功能的琥珀碱型Ti质粒pEHA105 (pTiBo542DT-DNA) ,此质粒含有vir基因(vir基因是T-DNA插入植物基因组必需的元件,pEHA105 (pTiBo542DT-DNA)质粒自身的T-DNA转移功能被破坏,但可以帮助转入的双元载体T-DNA顺利转移)。
pEHA105 (pTiBo542DT-DNA)型Ti质粒含有筛选标签:strep,赋予EHA105菌株链霉素抗性,适用于水稻、烟草等植物的转基因操作。
开发的EHA105电转感受态特别适用于大质粒的转化:经pCAMBIA2301质粒(size:11633bp)检测转化效率可达5×104cfu/μg;经pCAMBIA2301-ZH质粒(size:40kd)检测转化效率可达5×103cfu/μg。
EHA105农杆菌电转感受态细胞操作说明:
1. 0.2cm 电击杯和杯盖从储存液中拿出倒置于干净的吸水纸上5分钟,待其沥干水分,正置5分钟,使乙醇充分挥发,待乙醇挥发干净立即插入冰中,压实冰面,电极杯顶离冰面0.5cm以方便盖上杯盖,冰中静置5分钟充分降温。
2. 取-80℃保存的农杆菌感受态插入冰中5分钟,待其融化,加入1-5ug质粒DNA(质粒体积不大于6ul,应该用试剂盒抽提,双蒸水溶解),用手轻轻敲打管底混匀,立即插入冰中,用200ul枪头将感受态-质粒混合物快速移到电击杯中,盖上杯盖,空管保留待用。
3.启动电转仪,设置参数:C=25uF,PC=200ohm,V=2400V(此参数为Biorad 推荐,使用者也可按所用电转仪推荐的protocol操作),将电击杯快速放入电转槽中,电击完成快速插入冰中,加入700ul 无抗生素的LB并转移到感受态空管中,28℃振荡培养2~3小时。
4. 6000rpm离心一分钟收菌,留取100μl左右上清轻轻吹打重悬菌块涂布于含相应抗生素的LB或YEB平板上,倒置放于28℃培养箱培养2-3天(当平板只含有50ug/ml kan 时,28℃培养48h即可;平板中同时加入50ug/ml kan,20ug/ml rif 时,需28℃培养60h;如果使用的平板含有50ug/ml rif 则需要28℃培养72-90h)。